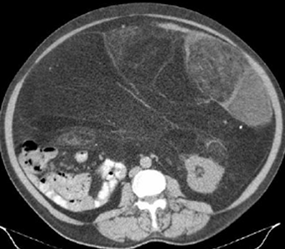

LIPOSARCOMA.
Es el 2º sarcoma mas frecuente de tejidos blandos, después del sarcoma pleomórfico indiferenciado. (28, 43).
Aparece entre la 6º y 7º décadas, en la zona profunda de las extremidades, con predominio en las piernas y el retroperitoneo. (43). (Fig 169).
En ecografía se aprecia imagen multilobulada, bien definida y heterogénea. (43).
En TAC y RM se encuentra una masa irregular de tejidos blandos, con predominio de contenido graso. Puede presentar septos mayores de 2 mm de espesor y lesiones nodulares hipointensas en T1 e hiperintensas en T2. Dependiendo del grado de diferenciación la señal es heterogénea y se encuentra realce del contraste. (28, 43). (Fig 170, 171, 172 y 173).
La transformación maligna de un lipoma es muy rara y se cree que corresponde a un mal diagnóstico inicial. (43).
Tiene alta recurrencia local por resección incompleta y produce metástasis pulmonares. (28, 43).
Fig 169. Liposarcoma.
Mayor frecuencia entre la 6º y 7º década. Lesión de tejidos blandos con predominio en las piernas y el retroperitoneo.

Fig 170. Liposarcoma.
TAC axial. Imagen heterogénea, con densidad de grasa y septos, que ocupa el espacio
para-renal posterior y desplaza el riñón, por liposarcoma retroperitoneal.
Fig 171. Liposarcoma.
TAC axial. Gran masa con densidad de grasa que ocupa gran porcentaje de la cavidad peritoneal. Presenta algunos septos gruesos y áreas heterogéneas, por liposarcoma.

Fig 172. Liposarcoma.
A: RM coronal en T1. Lesión de tejidos blandos, con zona hiperintensa en la parte inferior, por contenido graso.
B: RM coronal en T2. Extensa lesión heterogénea en la parte externa del muslo.
C: RM axial en T2. Lesión heterogénea de comportamiento agresivo, con infiltración de los músculos del compartimiento anterior y lateral, por liposarcoma.

Fig 173. Liposarcoma.
A y B: TAC axial. Prominencia asimétrica de los tejidos blandos en la pared costal izquierda. Muestra septos fibrosos gruesos y calcificación, correspondiendo a liposarcoma. (Flechas delgadas). En B hay nódulos pulmonares, por enfermedad metastásica. (Flechas gruesas).
Liposarcoma dediferenciado:
Esta lesión tiene 2 componentes uno de liposarcoma bien diferenciado y otro de sarcoma no adiposo. (43).
Mas frecuente en la 7º década y de predominio en el retroperitoneo. (43).
Es una lesión pleomórfica, de márgenes mal definidos, con signos de sangrado y necrosis y algunos pequeños focos de grasa. (43).
| Fecha de creación | Marzo 1 de 2011 |
| Fecha de actualización | Abril 5, 2015 |